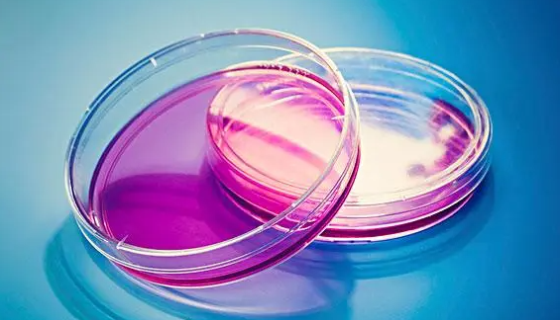
志贺氏菌在生化鉴定和血清学鉴定中的注意事项有哪些？

原代细胞羊肺动脉平滑肌细胞的培养操作有哪些注意事项?
羊原代肺动脉平滑肌细胞的培养核心是模拟体内生理微环境、减少污...

浅黄色马赛菌的代谢产物在环境修复方面的具体应用!
浅黄色马赛菌是Massilia属的微生物,原产地为中国。变形...

选择培养基的选择性要求对微生物实验的影响有哪些?
选择性直接决定实验成败:选得好,检出准、计数稳、鉴定可靠;选...

兔原代大隐静脉内皮细胞培养中如何鉴定细胞是否污染?
兔原代大隐静脉内皮细胞培养过程中,细胞污染的鉴定需结合肉眼观...
志贺氏菌在生化鉴定和血清学鉴定中的注意事项有哪些?
志贺氏菌的生化鉴定和血清学鉴定是确证菌种的核心步骤,操作中需...

大鼠肾小球系膜细胞原代培养与鉴定的注意事项有哪些?
大鼠肾小球系膜细胞常用于肾病发生机理的临床研究,也可用于构建...

单核细胞增生李斯特菌在食品中的污染来源及关键节点有哪些?
单核细胞增生李斯特菌在食品中的污染具有多途径、广范围、隐蔽性...

微生物菌种科罗拉多拟无枝酸菌的应用领域与发展前景如何?
科罗拉多拟无枝酸菌作为拟无枝酸菌属的重要成员,其应用前景主要...

大鼠小肠隐窝上皮细胞培养过程中需要注意的细节有哪些?
大鼠小肠隐窝上皮细胞培养过程中需要注意的细节及注意事项有哪些...